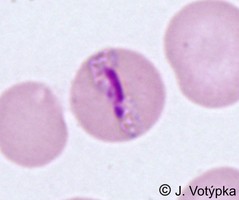
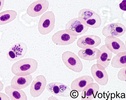

Haemospororida
Haemosporina
Jan Votýpka


This tree diagram shows the relationships between several groups of organisms.
The root of the current tree connects the organisms featured in this tree to their containing group and the rest of the Tree of Life. The basal branching point in the tree represents the ancestor of the other groups in the tree. This ancestor diversified over time into several descendent subgroups, which are represented as internal nodes and terminal taxa to the right.

You can click on the root to travel down the Tree of Life all the way to the root of all Life, and you can click on the names of descendent subgroups to travel up the Tree of Life all the way to individual species.
For more information on ToL tree formatting, please see Interpreting the Tree or Classification. To learn more about phylogenetic trees, please visit our Phylogenetic Biology pages.
close boxIntroduction
Order Haemospororidia Danilewsky, 1885
Within the phylum Apicomplexa, there are three groups of blood-borne protozoan parasites, including some species of the suborder Adeleorina (belonging to eight genera), all members of the suborder Haemosporina, and two genera (Lankesterella and Schellackia) of the suborder Eimeriorina. Haemosporidians (suborder Haemosporina) constitute a phylogenetically well-defined group with obligatory heteroxenous life cycle. Haemosporidian genera can be distinguished on the basis of the erythrocytic stage morphology, localization of endogenous development in the vertebrate host and the type of invertebrate vector. Merogony occurs in a wide range of vertebrate hosts (amphibians, reptiles, birds, and mammals) which serve as intermediate hosts, while sporogony takes place in a broad spectrum of blood-sucking Diptera or other haematophagous invertebrates.
Characteristics
Parasites are taken up with the blood meal by the vector, in which fertilization occurs and a motile zygote (ookinete) is formed. The ookinete actively penetrates the midgut wall, and at the midgut-haemocoel interface rounds up and transforms into the oocyst. Large oocysts of Plasmodium and Haemoproteus transmitted by mosquitoes and hippoboscid flies, respectively, subdivide their contents into several sporoblasts, from which hundreds of sporozoites bud off. Haemosporidians with small oocysts (Leucocytozoon and Haemoproteus species transmitted by biting midges) produce just one sporoblast with less than a hundred sporozoites. The oocyst ruptures and the freed naked sporozoites with rudimentary apical complex migrate into salivary glands, where they develop organelles such as rhoptries and micronemes.
Sporozoites injected into the blood of vertebrate hosts by the vectors transform into the exoerythrocytic meronts, known to develop most frequently in the liver, but are found also in the spleen, lungs, kidneys, heart, skeletal musculature and endothelium of other organs. The megalomeront stage is characteristic for the 2nd generation merogony of Leucocytozoon and Haemoproteus. The number of generations of exoerythrocytic meronts is never lower than two and the prepatent period (the interval between infection of the avian host by the infected vector and the first ability to detect parasites from the bird’s blood ergo ability to infect the next vectors) for the majority of species varies from 10 days to three weeks. Gametocytes capable of gametogenesis appear usually within two to six days after penetration of merozoites into the blood cells. The process of transformation of sporozoites and exoerythrocytic merozoites into trophozoites inside the host cells includes a rapid degeneration of the inner double membrane layer, subpellicular microtubules, polar rings, rhoptries and micronemes. Within erythrocytes, trophozoites of Plasmodium and Haemoproteus are localized in the parasitophorous vacuole and absorb host cell cytoplasmic content by micropyle. Haemosporidians with the intraerythrocytic development (Plasmodium and Haemoproteus) turn host hemoglobin into characteristic hemozoin pigment granules, easily discernible under the microscope. Pigment is absent in the Garnia species. Non-pigmented gametocytes are usually the only forms found in Saurocytozoon, while in the leukocytes pigmented forms may be found only occasionally. Fallisia produce non-pigmented asexual and gametocyte forms in leukocytes and thrombocytes.
Rapid growth of trophozoites ends through the formation of meronts. Members of the genus Leucocytozoon depart from the general scheme, as they infect a significantly wider range of host cells, and when infecting erythrocytes digest hemoglobin without the formation of hemozoin granules. Gametocytes develop only in the blood cells and individual malaria species infecting humans can be distinguished based on their morphology. The life cycle is closed when the gametocytes enter the appropriate vector during blood-feeding, in which they undergo fertilization and formation of the ookinete. Persistence of parasites in the host’s internal organs is species and genus specific. Among human species, Plasmodium vivax forms “hypnozoites” and relapses may occur even several years after infection. It appears that at least some avian parasites of the genera Haemoproteus and Leucocytozoon persist in birds for their whole life and relapses take place repeatedly at the beginning of host reproduction. Moreover, hypnozoites have been identified in some saurian Plasmodium species.
Discussion of Phylogenetic Relationships
The Apicomplexan order Haemosporina Danilewsky, 1885 contains a range of blood parasites including Leucocytozoon and Haemoproteus which are common in avian hosts and Plasmodium, the causative agent of malaria in mammals including humans, birds and lizards worldwide. According to various authors the order is composed of either only one family Plasmodiidae, or is split into four families. In the latter system the three closely related families are represented by Haemoproteidae (containing genus Haemoproteus), Garniidae (containing genus Fallisia), and Plasmodiidae (composed of 8 genera). The last single-generic family Leucocytozoidae is more distantly related to the above-mentioned groups.
The term ‘‘malaria parasite” is quite often used in current literature, however, it is not well defined. One suggestion (Valkiunas 2005) is that ‘‘malaria parasite” be restricted to species with asexual replication in the vertebrate blood (it means only to Plasmodium). However, common names should have phylogenetic significance. If the Plasmodium clade represents malaria parasites, then Hepatocystis, with very different morphology and life cycle, would also be included, while parasites much more similar to Plasmodium in life cycle and morphology (e.g. Haemoproteus) would be excluded. In such a situation several authors (Martinsen et al. 2008) propose that this problem can be resolved by including the monophyletic clade composed of Haemoproteus + Hepatocystis + Plasmodium under the rubric of malaria parasites. Following an alternative approach, usually maintained by veterinarians, Leucocytozoon is also included among malaria parasites.
In view of the long and little changed history of several reptile lineages (e.g. crocodilians), and in keeping with the hypothesis that speciation of parasites and their hosts is synchronous (‘co-speciation’) and that they have, topologically, the same phylogenetic trees, it is likely that reptiles host several “ancient” haemosporidian genera (e.g. Progarnia, a member of the family Garniidae), and that the haemosporeans of modern reptiles have evolved from such an organism. As birds stem from the saurischian dinosaurs, it is not surprising that there has been a parallel evolutionary process, with the extant avian Fallisia (the same species infect reptilian hosts), Leucocytozoon (clearly closely related to reptilian Saurocytozoon), Haemoproteus (the same species infect reptilian hosts; this genus is very similar to reptilian Haemocystidium) and the ‘Plasmodium’ species (subdivided into several subgenera infecting reptiles, birds, and mammals). Mammals evolved from a totally different and earlier reptilian stock than birds (most likely from Therapsida), and as the type species of the genus Plasmodium is human P. malariae, it might be argued that the inclusion of parasites in this genus should be restricted to the pigmented malarial parasites of mammals (but see also the Plasmodium page).
In addition to all the genera listed in the phylogenetic tree within haemosporidia, Bioccala and Biguetiella of bats (Biguetiella minuta; monotypic and the only known host of these parasites is the bat Hipposideros larvatus) were raised to the genus status by Landau et al. in 1984. Biguetiella minuta has very small intra-hepatocytic schizonts (less than 15 micron) and gametocytes of the "falciparum" type. Bioccala was described from bats from Thailand, but the species Bioccala deanei was later found also in a Colombian bat Eptesicus fuscus. Considering the circumstances that the status and validity of both genera remain ambiguous, they are not included into the phylogenetic tree.
More than several hundreds of haemosporidian species have been described based on morphological features of their blood stages and, occasionally, on the basis of a limited amount of information about their host specificity and other biological characters. However, recent molecular studies have revealed a remarkable genetic diversity among haemosporidian parasites, indicating that the number of species is likely to be substantially higher than can be distinguished by microscopy. It is generally true that many species are undergoing re-examination of their taxonomy by molecular data, and it seems likely that many of these species will be re-assigned after these studies have been completed. Although mostly excellent, the observations, deductions and conclusions of early protozoologists, were based on morphological and biological traits. Such characters do not necessarily describe the evolution as such and may not reflect real phylogenetic relationships between the taxa at various levels. Mostly ignoring the new data, the current classification, which is controlled by the rules of the zoological nomenclature, remains based on these historical conceptions.
Comparison of the diversity of apicomplexan protists with recent advances in molecular phylogeny clearly demonstrates the disproportionality of sampling, so far carried out, and stresses the total absence of most lineages and taxa (on the generic level) in recent phylogenies. The position of haemosporidians as well as their inner relationships are still unambiguous. This is further exacerbated by the fact that their sequences are highly divergent, frequently causing tree instability. Subsequently, most research tends to exclude them from phylogenetic analyses. Taxon sampling of haemosporidians is limited to the genera Haemoproteus, Leucocytozoon, and Plasmodium, while other genera such as Billbraya, Dionisia, Garnia, Mesnilium, Nycteria, Polychromophilus, Rayella, and Saurocytozoon have so far been ignored.
References
Landau I., Baccam D., Ratanaworabhan N., Yenbutra S., Boulard Y., Chabaud A.G. (1984) New Haemoproteidae parasites of Chiroptera in Thailand. Ann. Parasitol. Hum. Comp. 59:437-447.
Title Illustrations

| Scientific Name | Plasmodium gallinaceum |
|---|---|
| Location | Parasites in bird's blood |
| Image Use |
 This media file is licensed under the Creative Commons Attribution-NonCommercial License - Version 3.0. This media file is licensed under the Creative Commons Attribution-NonCommercial License - Version 3.0.
|
| Copyright |
© 2008 Jan Votýpka

|
| Scientific Name | Leucocytozoon sp. and Haemoproteus sp. |
|---|---|
| Location | Coinfection of parasites in buzzard's blood (Buteo buteo) |
| Image Use |
 This media file is licensed under the Creative Commons Attribution-NonCommercial License - Version 3.0. This media file is licensed under the Creative Commons Attribution-NonCommercial License - Version 3.0.
|
| Copyright |
© 2008 Jan Votýpka

|
| Scientific Name | Plasmodium malariae |
|---|---|
| Location | Parasite in human's blood |
| Life Cycle Stage | Band form of trophozoite (typical for P. malariae) |
| Image Use |
 This media file is licensed under the Creative Commons Attribution-NonCommercial License - Version 3.0. This media file is licensed under the Creative Commons Attribution-NonCommercial License - Version 3.0.
|
| Copyright |
© 2008 Jan Votýpka

|
About This Page
This page is being developed as part of the Tree of Life Web Project Protist Diversity Workshop, co-sponsored by the Canadian Institute for Advanced Research (CIFAR) program in Integrated Microbial Biodiversity and the Tula Foundation.
Jan Votýpka

Department of Parasitology, Charles University
Correspondence regarding this page should be directed to Jan Votýpka at
Page copyright © 2011 Jan Votýpka
 Page: Tree of Life
Haemospororida . Haemosporina .
Authored by
Jan Votýpka.
The TEXT of this page is licensed under the
Creative Commons Attribution-NonCommercial License - Version 3.0. Note that images and other media
featured on this page are each governed by their own license, and they may or may not be available
for reuse. Click on an image or a media link to access the media data window, which provides the
relevant licensing information. For the general terms and conditions of ToL material reuse and
redistribution, please see the Tree of Life Copyright
Policies.
Page: Tree of Life
Haemospororida . Haemosporina .
Authored by
Jan Votýpka.
The TEXT of this page is licensed under the
Creative Commons Attribution-NonCommercial License - Version 3.0. Note that images and other media
featured on this page are each governed by their own license, and they may or may not be available
for reuse. Click on an image or a media link to access the media data window, which provides the
relevant licensing information. For the general terms and conditions of ToL material reuse and
redistribution, please see the Tree of Life Copyright
Policies.
- First online 16 September 2008
- Content changed 18 May 2011
Citing this page:
Votýpka, Jan. 2011. Haemospororida . Haemosporina . Version 18 May 2011 (under construction). http://tolweb.org/Haemosporina/124976/2011.05.18 in The Tree of Life Web Project, http://tolweb.org/

Go to quick links
Go to quick search
Go to navigation for this section of the ToL site
Go to detailed links for the ToL site
Go to quick links
Go to quick search
Go to navigation for this section of the ToL site
Go to detailed links for the ToL site